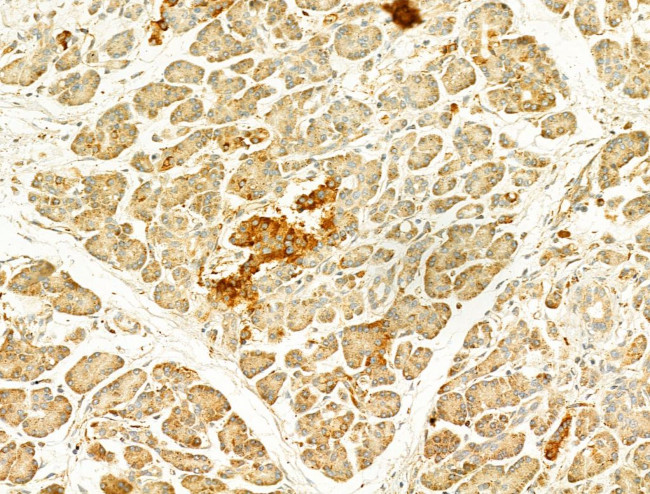
GZMB/GZMH Antibody in Immunohistochemistry (Paraffin) (IHC (P))

Search
Invitrogen
GZMB/GZMH Polyclonal Antibody
{{$productOrderCtrl.translations['antibody.pdp.commerceCard.promotion.promotions']}}
{{$productOrderCtrl.translations['antibody.pdp.commerceCard.promotion.viewpromo']}}
{{$productOrderCtrl.translations['antibody.pdp.commerceCard.promotion.promocode']}}: {{promo.promoCode}} {{promo.promoTitle}} {{promo.promoDescription}}. {{$productOrderCtrl.translations['antibody.pdp.commerceCard.promotion.learnmore']}}
图: 1 / 6
GZMB/GZMH Antibody (PA5-115323) in IHC (P)






Please note: We are reviewing Western blot images included in the antibody testing data in our catalog, including those provided by third parties. Unless expressly labeled or annotated as “raw-unedited”, Western blot images included in the antibody testing data in our catalog may have been edited, optimized or otherwise adjusted for presentation.
产品信息
PA5-115323
种属反应
宿主/亚型
分类
类型
抗原
偶联物
形式
浓度
规格
纯化类型
保存液
内含物
保存条件
运输条件
RRID
产品详细信息
Antibody detects endogenous levels of total Granzyme B/H.
靶标信息
GZMB/GZMH are members of the granzyme subfamily of proteins, part of the peptidase S1 family of serine proteases. The encoded preproprotein is secreted by natural killer (NK) cells and cytotoxic T lymphocytes (CTLs) and proteolytically processed to generate the active protease, which induces target cell apoptosis. This protein also processes cytokines and degrades extracellular matrix proteins, and these roles are implicated in chronic inflammation and wound healing. Expression of this gene may be elevated in human patients with cardiac fibrosis. [provided by RefSeq, Sep 2016]
仅用于科研。不用于诊断过程。未经明确授权不得转售。
篇参考文献 (0)
生物信息学
蛋白别名: C11; Cathepsin G-like 1; Cathepsin G-like 2; CCP-X; CCP1; CGL-2; CGL2; CSP-C; CTLA-1; CTLA1; CTSGL1; CTSGL2; Cytotoxic cell protease 1; Cytotoxic serine protease C; Cytotoxic T-lymphocyte proteinase; Cytotoxic T-lymphocyte proteinase 2; Fragmentin; Fragmentin-2; GLP I; GLP III; GLP-1; Granzyme B; Granzyme B(G,H); Granzyme H; Granzyme-2; granzyme-like protein 1; granzyme-like protein I; GZMH; GZMH/GZMB; HLP; Human lymphocyte protein; Lymphocyte protease; Natural killer cell protease 1; RNKP-1; SECT; T-cell serine protease 1-3E
基因别名: AI553453; CCP-1/C11; CCP1; CGL1; CGL2; CSPB; Ctla-1; CTLA1; CTSGL2; GRB; GZB; GZMB; GZMH; RNKP-1
UniProt ID: (Mouse) P04187, (Rat) P18291
Entrez Gene ID: (Mouse) 14939, (Rat) 171528